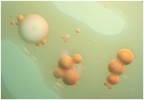
... ...

Commenti |
---|
 |
st di elis bolis commento di Francesco Ercolano |
|
La finestra tra le nuvole e l'oblò tra i fili d'erba.
Molto bella e molto ben composta.
L'unico mio dubbio è la scelta del bianco e nero, ma aspetta pareri più autorevoli.
Mi piace molto,
Franco
 |
|
|
 |
riflessi di paolo cadeddu commento di Francesco Ercolano |
|
Lo so di essere stupido e imbecille ma io l'avrei ruotata.
Amo molto questo genere di foto; la finestra con le tende bianche è meravigliosa.
Non so, sa di vecchi ricordi.
Molto bella
Complimenti,
Franco
 |
|
|
 |
Sfumature/Trio di Francesco Ercolano commento di Francesco Ercolano |
|
Avete pienamente ragione la serie non è proprio omogenea; avrei dovuto suddividerla in più volumi.
Queste serie che di tanto in tanto pubblico con la dicitura comune "Sfumature" hanno l'intento di mostrare le sfumature, le evoluzioni e i cambiamenti che hanno subito nel corso del tempo i soggetti protagonisti e il mio modo di affrontare il bianco e nero.
Sono davvero così felice e orgoglioso che queste meravigliose ragazze che ho visto crescere nel tempo mi abbiano portato in Home Page.
Davvero onorato
Ringrazio lo Staff, la Sezione, le ragazze e tutti voi che avete lasciato un commento.
Grazie di cuore a Tutti,
Franco
 |
|
|
 |
Interiors di Francesco Ercolano commento di Francesco Ercolano |
|
Carmine e la sua stanza di albergo
Napoli
Agosto 2020
Serie inedita
___________________________________________
Canon 5D MKII+Canon EF 24/105 IS
___________________________________________
Ho provato a mescolare, unire ritratto maschile, ritratto emotivo e architettura di interni.
Spero possa piacervi
Grazie sempre per l'attenzione,
Franco
____________________________________________
Suggerimenti e critiche sempre ben accetti |
|
|
 |
|
|
 |
Comincia la Sera di Francesco Ercolano commento di Francesco Ercolano |
|
Dal Contest "Albe e Tramonti" dedicato al nostro Arnaldo
Massalubrense (Na)
Marzo 2023
______________________________________________________
Canon 5D MKII+Canon EF 24/105 IS
ISO 200 f/7.1
1/800sec 35mm
______________________________________________________
Suggerimenti e critiche sempre ben accetti |
|
|
 |
|
|
 |
Geometria al Tramonto di iVhan commento di Francesco Ercolano |
|
Era una delle foto del contest che mi ha colpito di più; soprattutto l'interpretazione così personale del tema da affrontare.
Amo molto la tua Galleria e mi dispiace non essere molto presente.
Amo molto anche la tua personalizzazione delle foto con queste cornici così grandi; conferiscono continuità alla visione delle tue foto e regalano un tocco chic di vecchia polaroid.
Questa va tra le mie preferite
Complimenti e un saluto,
Franco
 |
|
|
 |
Sono Matassa di fabiopollio27 commento di Francesco Ercolano |
|
Un lavoro molto gradevole dal tessuto fortemente emotivo e denso di significati.
Mi ha ricordato una scultura bellissima che fotografai anni fa in visita al Nord dagli amici conosciuti qui sul forum.
Se ti dispiace la rimuovo subito.
Siamo fatti della stessa sostanza dei sogni, ma anche di matasse di smarrimenti e pentagrammi di musica.
Nonostante l'intento di autoritratto a mio modestissimo parere andrebbe in Artwork.
Sei sempre forte,
Franco
 |
|
|
 |
st di elis bolis commento di Francesco Ercolano |
|
Concordo con gli amici che mi hanno preceduto.
Bella ed elegante.
Mi colpisce la bellezza del riflesso, di come la texture liquida naturale trasfigura la realtà; quasi fosse percossa da vibrazioni musicali.
Complimenti,
Franco
 |
|
|
 |
|
|
 |
|
|
 |
ombre di randagino commento di Francesco Ercolano |
|
Sai che io l'avrei ruotata?
Se la giri sembrano le ombre di due scale antincendio spiegate...
Se ti dispiace la rimuovo subito, mi scuso in anticipo
Molto, molto bella
Complimenti,
Franco
 |
|
|
 |
|
|
 |
st di elis bolis commento di Francesco Ercolano |
|
Sembra un esplosione, un piccolo fuoco d'artificio in bianco e nero.
Amo molto queste interpretazioni vegetali in bn.
Se posso permettermi, avrei dato un pizzico di contrasto in più dando forza e spessore sia ai bianchi che ai neri.
Un salutone Elis,
Franco
 |
|
|
 |
Half di reddo commento di Francesco Ercolano |
|
Anche per me molto, molto bella..
Mi piace moltissimo che hai lasciato la pelle naturalissima
Ti lascio un pelo nell'uovo forse superfluo avrei cercato se possibile di includere per intero il bordo della maglietta.
I miei complimenti
Per me preferita,
Franco
 |
|
|
 |
bw portrait II di reddo commento di Francesco Ercolano |
|
Trovo lei molto bella ed intensa così come il bianco e nero; ricco di grigi e sfumature, mi piace moltissimo.
Mi dispiace ma non ricordo l'altra versione.
Qui c'è forse un pizzico di troppa post sugli occhi; ti sembrerà strano quello che ti sto per scrivere, mi regala la sensazione di troppa post.
Quasi tu avessi voluto esagerare per cercare il massimo della perfezione.
Non so se riesco a spiegarmi.
In ogni caso una foto molto bella.
Un salutone e scusa le chiacchiere,
Franco
 |
|
|
 |
... di 1962 commento di Francesco Ercolano |
|
Tecnicamente ineccepibile
Incredibile il dettaglio sulle pupille
Trovo solo lo sfondo un pizzico anonimo, freddo, non so spiegarmi.
Lascio la parola a più esperti, le tue incursioni nella macro mi piacciono molto.
Complimenti,
Franco
 |
|
|
 |
Alissa #1 di Riccardo Bruno commento di Francesco Ercolano |
|
Un lavoro di grande eleganza e fascino.
Mi piace particolarmente la cifra cromatica, la scelta dello sfondo e della posa.
Lei naturalmente bellissima.
I miei complimenti,
Franco
 |
|
|
|
Mario di Francesco Ercolano commento di Francesco Ercolano |
|
Canon 5D MKII+Canon EF 24/105 IS
ISO 400 f/4.5
1/2500sec 105mm
______________________________________________
Suggerimenti e critiche sempre ben accetti |
|
|
br>